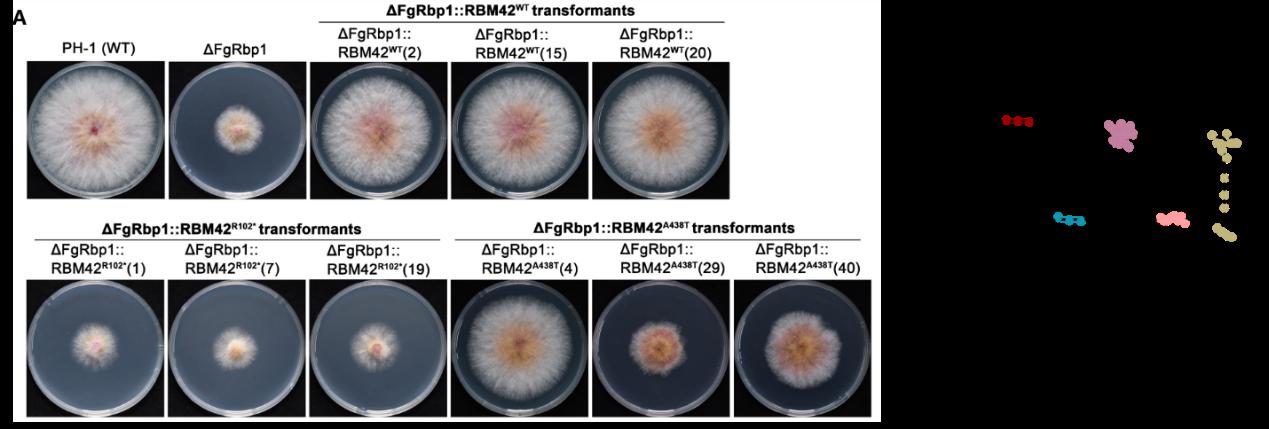

- 学校要闻
- 综合新闻
- 一线动态
- 专题报道
- 树立和践行正确政绩观学习教育
- 学习贯彻党的二十届四中全会精神
- 学习宣传贯彻习近平总书记重要贺信精神
- 复旦大学建校120周年
- 深入贯彻中央八项规定精神学习教育
- 本科教育教学审核评估
- 复旦大学第十六次党代会召开
- 我们这六年
- 我和我的老师
- 党纪学习教育
- “文化校历”之“学科周”
- 相辉校庆系列学术报告
- 学习贯彻习近平新时代中国特色社会主义思想主题教育
- 学习宣传贯彻党的二十大精神
- 喜迎二十大,见证新变化
- 浦江科学大师讲坛
- 深切缅怀杨福家老校长
- “第一个复旦”
- 学习贯彻六中全会精神
- 奋斗百年路 启航新征程
- 党史学习教育
- 学习贯彻五中全会精神
- 学习宣传贯彻总书记重要回信精神
- 赓续红色百年·365行动
- “四史”学习教育
- “三全育人”综合改革进行时
- 课程思政
- 你身边的“十三五”
- 脱贫攻坚 复旦在战
- 新生攻略
- 防控疫情 复旦在行动
- 复旦党员冲锋在前线
- 教师社会实践
- 学钟扬 忆钟扬
- 复旦智库
- 复旦人物
- 复旦讲堂
- 复旦书屋
- 相辉笔会
- 校史通讯
- 复旦管理学奖
- 上海论坛
- 工博会上的复旦
- 历史数据
- 视频新闻
- 图说复旦
- 新闻排行
- 媒体视角
- 专家视点
- 复旦校报
- 声动复旦
- 科教扫描
- 通知公告
- 文化校历